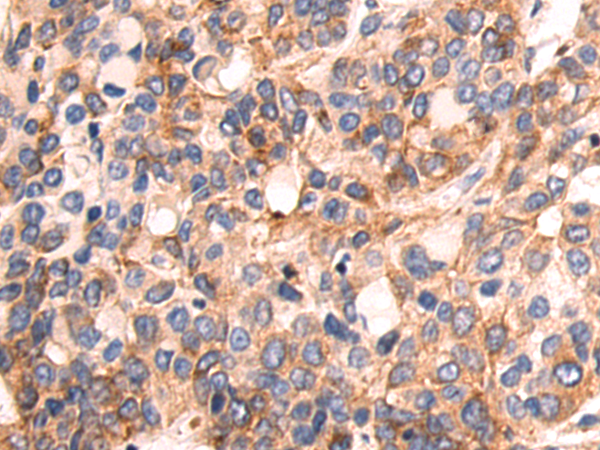
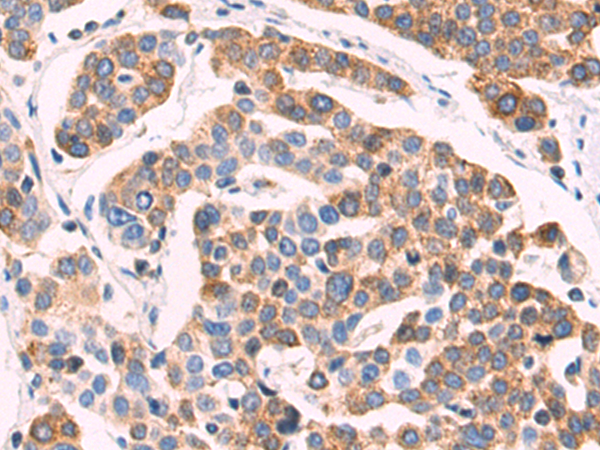

-
分类: 科研抗体货号: P02554别名:应用: IHC反应种属: Human, Mouse, Rat
-
分类: 科研抗体货号: P02471别名: OSM; C7orf22; PP10187应用: IHC反应种属: Human
-
分类: 科研抗体货号: P02553别名:应用: WB,IHC反应种属: Human, Mouse
-
分类: 科研抗体货号: P02469别名: JM11应用: WB反应种属: Human, Mouse
-
分类: 科研抗体货号: P02552别名: COPZ; CGI-120; HSPC181; zeta-COP; zeta1-COP应用: WB反应种属: Human, Mouse
-
分类: 科研抗体货号: P02571别名: HVLP应用: WB,IHC反应种属: Human
-
分类: 科研抗体货号: P02533别名:应用: WB,IHC反应种属: Human, Mouse, Rat
-
分类: 科研抗体货号: P02569别名: CPSF160; P/cl.18; HSU37012应用: IHC反应种属: Human, Mouse
-
分类: 科研抗体货号: P02532别名: ENTH; EPN4; EPNR; CLINT应用: WB,IHC反应种属: Human, Mouse
-
分类: 科研抗体货号: P02518别名: HNK1ST; HNK-1ST应用: WB,IHC反应种属: Human, Mouse, Rat

鄂公网安备42018502007531号
鄂公网安备42018502007531号

